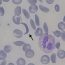

Faire de la #drépanocytose une maladie connue de tous ! 30 000 Francais sont concernés. Vice-Président du Groupe d’Etudes maladies rares, je signe cette Tribune avec des collègues. #AgirpourlaDrépanocytose #drepano #sicklecellhttps://t.co/Zi5ykSacj9 via @lejdd — MOREL A L'HUISSIER (@MORELPIERRE) June 19, 2021 MOREL A L’HUISSIER – Député de la Lozère, Secrétaire de la Commission des lois